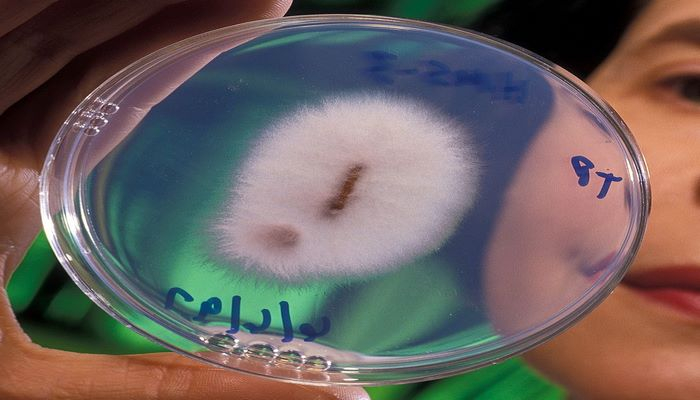

Havadan qızıl yaradan unikal göbələk tapıldı
Avstraliya Dövlət Elmi və Tətbiqi Araşdırma Birliyinin alimləri əvvəllər tanınmayan göbələk növü ilə əlaqədar səs-küylü bəyanat veriblər.
Məqalədə qızıl birləşmələrini udmaq və onları təmiz metala çevirməyə qadir olan mikroskopik göbələk növünün aşkarlanmasından bəhs edilir.
Yeni göbələk növü Fusarium oxysporum adlanır. Onlar Avstraliyanın qərbində tapılıb və ətraf mühitdə həll olmuş qızıl birləşmələrindən istifadəsi ilə bağlı qeyri-adi bacarıq nümayiş etdirib.
İş burasındadır ki, göbələklər yüksək reaktiv tərkibli hidrogen peroksid molekulları ayırır ki, onlar da onu oksidləməyə və iona çevrilməsinə məcbur edir. Bundan sonra təmiz metal kompleksləri formalaşır. Buna baxmayaraq parlaq qızıl hissəcikləri göbələk tellərinin səthini örtür.
Hazırda mütəxəssislər göbələklərin bu çevrilmədən nə üçün istifadə etdiyini sübut edə bilmirlər.

























Şərhlər
Şərhləri göstər Şərhləri gizlət